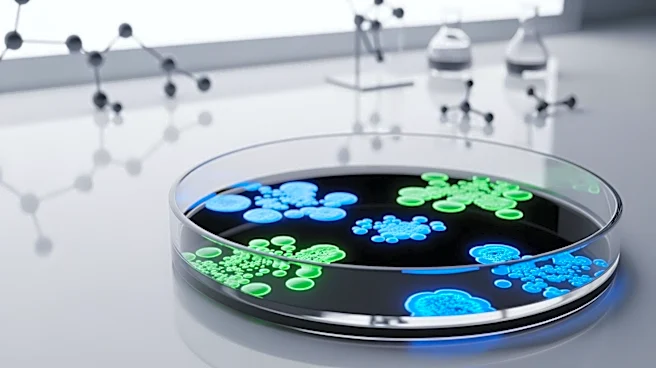
Shionogi Secures U.S. Government Contract to Combat Drug-Resistant Bacterial Threats

Competitive eating contests have become a unique cultural phenomenon, particularly in countries like Japan and the United States. These events, where participants consume large quantities of food in a limited time, have sparked both fascination and controversy. While they offer entertainment and a sense of community, they also raise questions about societal values and health implications.
Entertainment and Community
Competitive eating contests are often seen as a form of entertainment,
drawing large crowds and media attention. Events like the Nathan's Hot Dog Eating Contest have become annual traditions, attracting spectators who enjoy the spectacle of watching competitors push their limits. These contests provide a sense of community, bringing together people from diverse backgrounds to celebrate a shared interest.
In Japan, competitive eating is a popular television spectacle, with shows dedicated to showcasing the skills of top eaters. The appeal lies in the combination of skill, endurance, and the sheer audacity of consuming massive amounts of food. This form of entertainment has transcended cultural boundaries, with international competitors participating in events worldwide.
Criticism and Controversy
Despite their popularity, competitive eating contests have faced criticism for promoting unhealthy behaviors. Health experts warn of the potential risks, including obesity, diabetes, and other health issues associated with consuming excessive amounts of food. The act of eating large quantities in a short time can lead to gastric distress and other medical complications.
Socially, these contests are often viewed as wasteful, with critics arguing that they reflect a culture of excess. The juxtaposition of competitive eating with global issues like hunger and food scarcity has led some to question the ethics of such events. Additionally, the portrayal of gluttony as entertainment can be seen as a reflection of consumer culture, particularly in the United States.
The Future of Competitive Eating
As competitive eating continues to grow in popularity, it faces the challenge of balancing entertainment with health and ethical considerations. Organizations like the Federation of Competitive Eaters (FAOCE) have implemented safety standards to protect participants, acknowledging the potential risks involved. These measures aim to ensure that the sport remains safe and enjoyable for all involved.
Looking ahead, competitive eating may evolve to address these criticisms, potentially incorporating healthier food options or promoting moderation. As society becomes more health-conscious, the future of competitive eating will likely depend on its ability to adapt to changing cultural values. Despite the controversies, competitive eating remains a captivating spectacle, offering a unique blend of entertainment and cultural commentary.